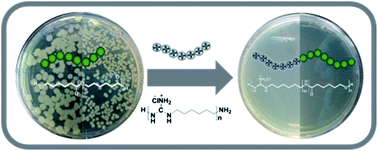

Dual functional antibacterial and biodegradable caprolactone (CL) based oligomers were prepared by ring-opening polymerization of caprolactone using a polyguanidine macroinitiator. Primary amino (–NH2) end-groups of linear poly(hexamethylene guanidine) hydrochloride (PHMG) acted as initiating sites for caprolactone polymerization leading to block copolymers which combine the antibacterial properties of PHMG with degradability provided by PCL. The block structure of the material was confirmed with 2D NMR and MALDI-ToF-MS. Furthermore, the material exhibited temperature dependent solubility (upper critical solution temperature) in polar solvents such as methanol. The oligomers showed high antibacterial activity (reduction of bacterial cells was more than 3 orders of magnitude) even at short incubation times depending on the concentration and PHMG : PCL ratio while maintaining enzymatic degradability and biocompatibility.